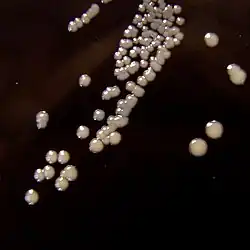

Coqueluche
| Causes | Bordetella pertussis |
|---|---|
| Transmission | Transmission aéroportée (d) et contamination par les sécrétions respiratoires (d) |
| Incubation min | 7 j |
| Incubation max | 21 j |
| Symptômes | Rhinorrhée, fièvre, toux, apnée, fatigue et vomissement |
| Traitement | Antibiotique |
|---|---|
| Médicament | Érythromycine, déméclocycline, guaïfénésine, azithromycine et clarithromycine |
| Spécialité | Infectiologie |
| CISP-2 | R71 |
|---|---|
| CIM-10 | A37 |
| CIM-9 | 033 |
| DiseasesDB | 1523 |
| MedlinePlus | 001561 |
| eMedicine |
967268 ped/1778 |
| MeSH | D01491 |
| Patient UK | Whooping-cough-pro |
Mise en garde médicale
La coqueluche est une infection respiratoire bactérienne peu ou pas fébrile de l'arbre respiratoire supérieur, mais d'évolution longue et hautement contagieuse. Deux bactéries du genre des Bordetella sont responsables des syndromes de la maladie chez l'être humain : Bordetella pertussis et Bordetella parapertussis.
C’est une maladie longue (quatre à huit semaines, après une période d'incubation d'une semaine) et éprouvante (caractérisée par de violentes quintes de toux dont le paroxysme évoque le chant du coq).
La vaccination a profondément modifié l'épidémiologie de la coqueluche, en réduisant fortement l'incidence et la gravité de la coqueluche. Cependant, dans les pays à forte couverture vaccinale, on observe une résurgence de la coqueluche survenant chez les jeunes nourrissons non encore complètement vaccinés.
Étymologie
L’origine du terme coqueluche est obscure. Coqueluche apparait en 1414, ce serait une altération de capuche, les malades se couvrant la tête d'une coiffe ou se sentant la tête lourde et chaude comme s'ils portaient un capuchon. Une autre étymologie populaire est la toux évoquant le chant du coq (cocorico)[1],[2].
Selon les pays, la toux est comparée à celle d'un chien (tosse canina) en Italie, d'un loup (Wolfshusten) ou d'un âne (Eselshusten) en Allemagne[3].
Dans son sens médical, le terme coqueluche est fixé au XVIe siècle. À la fin du XVIIIe siècle, le mot coqueluchon désigne les plumes sur la tête d'un oiseau (Buffon), puis tombe dans l'oubli. Le ou la malade atteint de coqueluche est un coquelucheux ou une coquelucheuse[2].
Moins usités sont les termes coqueluchette pour désigner une coqueluche minime et hypercoqueluche pour une forme grave ou maligne ; coqueluchoïde qualifie ce qui ressemble à la coqueluche[4].
À partir du XVIIe siècle, coqueluche signifie aussi « personne dont tout le monde s'éprend » ou être la coqueluche de… (même emploi métaphorique que être coiffé, être toqué de…)[2].
Agent causal
L'agent causal de la coqueluche est Bordetella pertussis, du genre Bordetella (qui comprend une dizaine d'espèces) de la famille des Alcaligenaceae.
Microbiologie
B. pertussis est classiquement identifié comme le seul agent responsable de la coqueluche humaine, l'Homme étant le seul réservoir de B. pertussis[5]. D'autres espèces voisines comme B. parapertussis, B. olmesii peuvent causer des toux ressemblant à la coqueluche mais sous des formes mineures. B. bronchoseptica peut infecter des personnes immunodéprimées[6].
Si B. pertussis n'infecte que les humains, d'autres espèces peuvent infecter les oiseaux (B. avium et B. hinzii), B. parapertussis et B. bronchoseptica pouvant infecter d'autres mammifères que l'homme[6].
Les trois espèces B. pertussis, parapertussis et bronchoseptica, sont génétiquement très proches, et des indices suggèrent que B. pertussis aurait évolué à partir d'une souche ancestrale de B. bronchoseptica (divergence qui se serait produite au moyen âge)[7]. La bactérie aurait évoluée par réduction du génome avec acquisition de gènes de virulence permettant de passer d'une adaptation générale aux mammifères à une adaptation stricte à l'Homme[8].
Mécanismes d'action
Les Bordetella sont des bactéries pathogènes pour l'arbre respiratoire des mammifères. Une fois dans les voies respiratoires, la bactérie Bordetella pertussis se multiplie sur l’épithélium respiratoire au niveau des cils de la trachée et des bronches. Elle diffuse plusieurs toxines spécifiques qui provoquent la maladie : la coqueluche est une maladie toxinique.
Ces toxines, produites et sécrétées par les Bordetella, sont des adhésines qui permettent d'adhérer à la surface des cellules de l'hôte, et des cytotoxines qui les détruisent. Les mécanismes précis restent encore mal connus, par exemple pour expliquer les quintes paroxystiques de la coqueluche. La principale toxine de B. pertussis est la toxine PT (Pertussis toxin (en)) ; outre ses effets toxiques directs, elle inhiberait la réparation des lésions inflammatoire (ce qui expliquerait la longue durée de la maladie), tout en étant fortement immunogène (d'où l'utilisation de PT inactivée dans les vaccins)[6],[7].
Mode de transmission

La coqueluche est une maladie infectieuse très contagieuse surtout à son début, lorsqu'elle reste inaperçue ou confondue avec un simple rhume. Son nombre de reproduction R0 est de 12 à 17, ce qui en fait la maladie la plus contagieuse avec la rougeole[6]. Son taux d'attaque est de 70-100 % pour les personnes vivant sous le même toit[9].
La transmission s'opère par voie aérienne, la bactérie à l'origine de la maladie se propageant par des gouttelettes de salive expulsées lors de la toux ou d'un éternuement. Les patients non traités peuvent transmettre l'infection pendant 3 semaines ou plus après l'apparition des premières quintes de toux typiques, même si la contagiosité diminue rapidement après le stade catarrhal[10].
Avant l'ère vaccinale (ou dans les pays à faible couverture vaccinale), la principale source de contamination est constituée par les enfants d'âge préscolaire ou scolaire. Depuis la vaccination, les adolescents et les adultes sont devenus des sources importantes de transmission de B. pertussis aux nourrissons non vaccinés. Pour les nourrissons de moins de 6 mois, les études montrent que les contacts familiaux sont en cause pour la grande majorité des cas (plus de 75 %)[10].
Une toux chronique non diagnostiquée sur trois chez l'adulte est le fait d'une personne atteinte de coqueluche[11].
Dans tous les cas, une enquête doit être menée autour du sujet malade pour dépister les contaminateurs et les cas secondaires. Ceci permet une action préventive en traitant rapidement les autres malades pour éviter la propagation de la maladie, notamment chez les sujets à risque : nouveau-nés, petits nourrissons et femmes enceintes, asthmatiques…
Formes cliniques
Les symptômes de la coqueluche sont variables selon l'âge et le statut vaccinal des individus[12].
La coqueluche est une maladie immunogène, mais pas pour toute la vie. L'immunité conférée par l'infection naturelle dure en moyenne 12 à 15 ans (extrêmes 3 ans et demi à 30 ans), alors que la protection vaccinale est de l'ordre de 8 à 10 ans[6],[13].
Dès lors, il existe un déclin immunitaire avec le temps. Des adolescents, adultes et personnes âgées, anciennement vaccinés sont susceptibles de présenter ou de transmettre une coqueluche[6].
Forme classique de l'enfant non vacciné
La période d'incubation dure de 7 à 10 jours dans la plupart des cas, mais qui peut aller jusqu'à 3 ou 4 semaines dans quelques cas. Classiquement, la maladie évolue en trois phases[14],[6].
Phase d'invasion ou catarrhale
La phase d'invasion dure une à deux semaines. Elle se caractérise par des signes non spécifiques, évoquant une infection rhino-pharyngée : rhinite, rhinorrhée, éternuement, toux, la fièvre est absente ou modérée… À son début, la coqueluche peut être confondue avec un simple rhume[6],[15].
À la différence d'une infection virale banale, la toux s'aggrave progressivement pour devenir spasmodique (quinte de toux), émétisante (accompagnée de vomissement), et nocturne[13].
Phase paroxystique
Elle dure en moyenne 4 à 6 semaines. La toux s'est organisée en paroxysmes caractéristiques de la coqueluche. Chaque paroxysme comprend[14],[6] :
- une série de secousses expiratoires sonores, produites au cours d'une même expiration, qui interdit l'inspiration ;
- suivie d'une longue reprise inspiratoire, bruyante (« le chant du coq »).
- ces paroxysmes épuisent et suffoquent, prédominant la nuit, ils se terminent par des expectorations (mucosités semblables à du blanc d'œuf cru). Un vomissement peut apparaitre à la fin de la quinte : il est alimentaire ou muqueux selon le contenu de l'estomac[16].
Les quintes de toux peuvent être déclenchées par de multiples stimuli : alimentation, émotion, cri, pleurs, rire, effort… Leur nombre augmente progressivement jusqu'à plus de 50 par jour[13].
Entre les quintes, l'enfant reste asymptomatique et reprend son repos ou ses activités, il n'y a pas de fièvre. Les auteurs historiques décrivaient le « seul signe objectif qui affirme une coqueluche sans avoir entendu la quinte », l'ulcération sublinguale située au frein lingual, là où le frein frotte brutalement aux incisives inférieures au cours de quintes répétées[16].
Phase de déclin et de convalescence
Les quintes diminuent de durée, de fréquence et d'intensité, mais une toux chronique, non paroxystique, peut durer encore 6 semaines. Dans les mois qui suivent, une infection virale respiratoire banale peut déclencher chez l'enfant un tic coqueluchoïde (toux reproduisant le modèle paroxystique)[14],[6].
Forme du nourrisson
Chez le petit nourrisson non encore, ou incomplètement vacciné, en général de moins six mois, le tableau clinique est moins typique. Après une phase catarrhale, la toux devient quinteuse, le plus souvent sans « le chant du coq », les apnées et les accès de cyanose sont au premier plan, nécessitant une surveillance de tous les instants.
Avant l'âge de trois mois, ces quintes sont mal tolérées. Elles peuvent être asphyxiantes, avec bradycardie profonde et vomissements compromettant l'alimentation, avec déshydratation et dénutrition[13].
En France, l'hospitalisation des nourrissons de moins de six mois, suspects de coqueluche, est quasi systématique (en 2013, 94 % d'entre eux ont été hospitalisés, dont 30 % en réanimation à cause de complications, avec 3 % de létalité[12]). En réanimation, il s'agit surtout de nourrissons de moins de trois mois atteints de coqueluche maligne potentiellement mortelle (détresse respiratoire, tachycardie, défaillance multiviscérale…)[13].
Forme de l'adolescent et de l'adulte
Chez l'adolescent et l'adulte (déjà vacciné, ayant eu la coqueluche, ou les deux), la coqueluche est variable, selon l'immunité protectrice résiduelle. Elle peut se présenter de façon classique, mais plus souvent sous une forme mineure, difficile à reconnaitre par les cliniciens, par exemple devant une toux banale qui dure, faisant penser à une bronchite ou un équivalent d'asthme. Le principe est d'évoquer une coqueluche devant une toux sans cause évidente, qui s'aggrave après la première semaine ou qui persiste simplement plus de trois semaines[6],[14].
Formes compliquées
En dehors de la coqueluche maligne des petits nourrissons non encore vaccinés, les complications de la coqueluche sont rares ou très rares depuis le recours à la vaccination. Néanmoins la coqueluche peut entraîner plusieurs types de complications[6],[14].
- Les complications mécaniques sont liées à l'intensité de la toux (hyperpression thoracique) : hernie abdominale, pneumothorax, fracture costale...
- Les complications infectieuses (surinfections virales et bactériennes) s'annoncent par l'apparition d'une fièvre : otite, pneumonie, atélectasie avec surinfection...
- Les complications neurologiques surviennent surtout chez les nourrissons : convulsions, encéphalopathie...
Le décès peut survenir chez les petits nourrissons hospitalisés, et plus rarement chez les adultes âgés (plus de 49 ans) souffrant aussi de comorbidités[6].
Diagnostic
Devant une forme classique, le diagnostic clinique est très évocateur et souvent suffisant (caractéristiques de la toux, sa durée, identification d'un contaminateur), mais les autres formes moins typiques nécessitent des examens de confirmation[13].
Diagnostic différentiel
Dans les cas atypiques, il faut discuter d'autres causes de toux rebelle, en fonction du terrain[14] :
- chez l'enfant : corps étranger trachéo-bronchique chez le jeune enfant (âgé de plus de 6 mois), reflux gastro-œsophagien, asthme, tuberculose, mucoviscidose, laryngotrachéite infectieuse, déficit immunitaire ;
- chez l'adulte : reflux gastro-œsophagien, toux psychogène, causes infectieuses, tumorales, allergiques, médicamenteuses.
Un syndrome coquelucheux (forme clinique similaire à une coqueluche) peut se voir plus rarement dans d'autres infections respiratoires : à Chlamydia trachomatis, à virus respiratoire syncitial (bronchiolite), à adénovirus[14].
Examens d'orientation
À la phase paroxystique, l'hémogramme montre une hyperleucocytose (de 15 000 à plus de 50 000 /mm3), et une forte lymphocytose (60 à 90 %). Une thrombocytose est fréquente chez le nourrisson[14].
La radiographie pulmonaire peut montrer des opacités près des bronches hilaires, une atélectasie, plus rarement un emphysème pulmonaire ou un emphysème sous-cutané cervical (au niveau du cou)[14].
Diagnostic biologique
La confirmation biologique est indiquée pour plusieurs raisons : arrêt de la transmission par le traitement précoce des personnes contagieuses (celles qui toussent) ; protection des personnes en contact avec la personne infectée ; prise en charge précoce des sujets à risque de complications (jeunes nourrissons)[17].
PCR et mise en culture
Dans les trois premières semaines de toux, le germe est identifié dans les sécrétions respiratoires (prélèvement naso-pharyngé par aspiration ou écouvillonnage). Cet examen est particulièrement utile lors de la phase catarrhale et dans les formes atténuées de la coqueluche[14]. Cette limite de trois semaines explique que, le plus souvent, le diagnostic de certitude est porté sur des cas secondaires (cas contaminés par un cas index), et non pas sur le cas index[12].
La technique de PCR en temps réel (PCR tr) utilisée en routine identifie les Bordetella, sans distinction d'espèces, d'autres PCR tr ciblent des séquences très spécifiques qui permettent de les distinguer (pertussis, parapertussis, holmesi, bronchiseptica)[14].
La mise en culture sur milieux spécifiques (milieu Bordet-Gengou, milieu Regan Lowe) permet, en sus de l'identification, de suivre l'évolution des populations bactériennes : résistance aux antibiotiques, pression de sélection induite par la vaccination[12].
Sérologie
La sérologie identifie les anticorps spécifiques dirigés contre la toxine de B. pertussis dans le sérum d'un sujet non vacciné. Il existe toutefois un manque de standardisation qui rend leur interprétation incertaine (pas de distinction entre anticorps induits par la maladie, et ceux d'origine vaccinale ou maternelle – pour les nourrissons de moins de six mois –). Les tests commercialisés manquent de spécificité et sensibilité [12],[9].
La sérologie n'est plus recommandée en France, où elle n'est plus remboursée depuis 2011. La seule sérologie validée est celle du centre national de référence (CNR), réalisée dans le contexte de cas groupés[14].
Épidémiologie
Pour l'épidémiologie historique, voir la section Histoire. Au XXIe siècle, malgré une couverture vaccinale mondiale élevée (estimée en 2014 à 86 %), la coqueluche reste une maladie endémique avec de fréquentes épidémies sporadiques survenant en différents points du monde, touchant les pays en développement et les pays développés[6],[10].
Surveillance
La surveillance et l'estimation de la maladie se heurte à plusieurs difficultés. De nombreux pays développés ont des systèmes limités de surveillance, des pays en développement ne disposent pas de laboratoires pour confirmer le diagnostic de coqueluche (notamment la PCR). De plus, l'OMS signale que les définitions standards de cas cliniques de coqueluche ne sont pas appliqués de façon uniforme par tous les pays[6].
En France, la surveillance épidémiologique systématique de la coqueluche a été supprimée en 1986 en raison de la quasi-disparition de la coqueluche (transmission d'enfants à enfants). Après 10 ans d'arrêt, avec la recrudescence de la maladie (par transmission adultes-adolescents à nouveau-nés) la surveillance en France est principalement assurée par trois systèmes[18] :
- le Centre National de référence (CNR) de la coqueluche et des autres bordetelloses (surveillance microbiologique des infections à Bordetella)[19], créé en 1993[12] ;
- le réseau RENACOQ (créé en 1996) composé de 43 centres hospitaliers pédiatriques en 2015, représentant 30 % des hospitalisations pédiatriques (de 1996 à 2015, signalement des cas de moins de 17 ans, et depuis 2016, uniquement les nourrissons hospitalisés de moins de 6 mois)[12] ;
- le réseau Sentinelles composé de médecins libéraux qui signalent la coqueluche depuis 2017 (cas confirmés par PCR)[18].
Données
La coqueluche touche toutes les tranches d’âge, mais ses manifestations cliniques varient en fonction de l’âge. Elle peut survenir chez des individus préalablement vaccinés ou qui ont déjà été infectés, mais en ce cas, le tableau clinique est atténué. Dans les populations très majoritairement vaccinées, la population la plus vulnérable et la quasi-totalité des décès concernent les nourrissons de moins d'un an tandis que, chez les populations non vaccinées, la maladie touche plutôt les enfants plus âgés. La coqueluche est une maladie qui peut mettre en jeu le pronostic vital du nourrisson avec un taux de létalité de 1 à 3 %[14].
La coqueluche évolue par cycles de recrudescence tous les 3 à 5 ans[20]. Si la vaccination a nettement réduit l'incidence et la gravité de la maladie, elle n'a guère changé cette périodicité, ce qui suggère qu'elle a peu d'impact sur la circulation de B. pertussis[21].
Niveau mondial

En 2008, L'Organisation mondiale de la santé (OMS) donne une estimation de 16 millions de cas de coqueluche dans le monde, dont 95 % dans les pays en développement, avec 195 000 enfants décédés de cette maladie[22].
En 2013, l'OMS recense officiellement 136 036 cas de coqueluche en 2013[6] dont le décès de 63 000 enfants de moins de 5 ans[10].
L'écart entre les estimations et les signalements officiels tient à une incertitude considérable due, entre autres, à la rareté des données de surveillance fiables en provenance des pays en développement[10].
Une résurgence de la coqueluche est observée en particulier chez les adultes et les adolescents qui étaient anciennement vaccinés[23]. Cette résurgence varie selon la couverture vaccinale, les modifications vaccinales (type de vaccin, calendrier vaccinal) et l'utilisation de la PCR (diagnostic plus précis qui fait reconnaitre des cas de coqueluche auparavant non décomptés)[21].
Pays développés
.jpg)
Aux États-Unis, une résurgence de coqueluche commence dans les années 1980. Dans les années 2010, les cas signalés fluctuent entre 20 000 et plus de 40 000 cas par an. Cette résurgence s'observe en particulier chez les adolescents et les adultes anciennement vaccinés. Le même phénomène s'observe au Canada, mais avec quelques différences (résurgence plus ou moins fortes selon les tranches d'âge), ce qui serait lié à des différences de calendrier vaccinal avec les États-Unis (âges de la primo-vaccination, et des doses de rappel)[21].
En Australie, cette résurgence s'est manifestée avec une épidémie survenue de 2008 à 2012 (173 cas pour cent mille habitants en 2011), et en Nouvelle-Zélande avec des épidémies en 2011-2013 et 2017-2018[21].
En Europe, cette résurgence se produit une quinzaine d'années après celle des États-Unis. Selon l'ECDC, plus de 40 000 cas ont été signalés en 2012, et plus de 35 000 en 2018. Les augmentations les plus fortes sont observées en Pologne, au Pays-Bas, et en Angleterre[21].
En Suisse, de 2010 à 2014, 8 700 cas de coqueluche ont été enregistrés en moyenne chaque année. La part des adolescents et des adultes parmi les patients tend à augmenter. Environ trente enfants sont hospitalisés chaque année à cause d'une coqueluche, surtout des nourrissons, et quatre décès liés à la coqueluche ont été déclarés au cours des 15 dernières années[24].
En France, sur la période 2017-2020, selon le Réseau Sentinelles, le taux d'incidence est estimé à 17 pour cent mille habitants en 2017, puis 10 et 15 pour cent mille habitants en 2018 et 2019. Du fait de la pandémie de COVID-19, ce chiffre est tombé à 3/100 000 en 2020. Le pic d’incidence durant les années 2017-2019 avait principalement lieu au cours des mois de mai et juin. Il s'agit cependant d'une sous-estimation, compte tenu des spécificités du Réseau Sentinelles (non prise en compte des cas asymptomatiques, par exemple)[25].
Selon le réseau Renacoq, entre 2010 et 2015, l'incidence moyenne annuelle de la coqueluche en France serait de 276 pour cent mille, dont 31 à 42 % chez les nourrissons de moins de 3 mois[14].
Depuis le début de l'année 2024, au 29 juillet 2024, un total provisoire de 28 décès a été rapporté en France, dont 20 enfants (18 âgés de moins de 1 an) et huit adultes (âgés de 51 à 86 ans). Le plus grand nombre de décès a été observé en juillet avec 9 décès[26].
Pays en développement
À de rares exceptions près, dans les pays d'Afrique, de la méditerranée orientale et d'Asie, les systèmes nationaux de surveillance de la coqueluche sont peu fiables (suspicion clinique sans confirmation en laboratoire) ou inexistants[21].
En Afrique, des études indiquent que la coqueluche continue de circuler parmi les enfants africains, malgré les programmes de vaccination, avec un risque accru chez les malnutris et les infectés par VIH. En Asie, des épidémies sont survenues au Pakistan (2004-2006), en Inde (2007), Afghanistan (2007-2008), et Japon (2008-2011) ; puis dans les années 2010 en Chine, à Taïwan et en Corée du Sud[21].
En Amérique latine, la qualité des systèmes de surveillance est variable ou incertaine. Une résurgence parait s'observer en Amérique du Sud (Argentine, Brésil, Pérou, Chili) mais pas ou peu en Amérique centrale (Salvador, Honduras, Guatemala, Panama)[21].
Explications
Les raisons d'une résurgence de la coqueluche sont mal comprises, et attribuées à de nombreux facteurs[27]. Le principal facteur généralement reconnu est la durée limitée de la protection vaccinale[8].
Dans les pays à faible couverture vaccinale, la transmission dominante de la coqueluche reste celle d'enfants à enfants. L'incidence de la maladie est forte, avec un pic unique autour de la tranche d'âge des enfants de six ans. Dans les pays à forte couverture vaccinale, l'incidence de la maladie est beaucoup plus faible, mais le pic unique des enfants a été remplacé par un double pic : celui des nourrissons non ou incomplètement vaccinés (cas graves) et celui des jeunes adultes (cas atypiques de toux banale)[8],[14].
Durée limitée de la protection vaccinale
La protection conférée par les vaccins à germe entier est de l'ordre de 5 à 14 ans, et celle des vaccins acellulaires de 4 à 7 ans. À partir des années 1990, les vaccins acellulaires (plus sûrs que les premiers) ont progressivement remplacé les vaccins à germe entier[9] (voir section Histoire).
Les personnes anciennement vaccinées, ayant perdu leur immunité en l'absence de rappels naturels ou vaccinaux, peuvent représenter un réservoir important de la maladie et devenir une source majeure de transmission aux nourrissons. Ce phénomène est à l'origine de diverses stratégies vaccinales, telles que l'instauration de doses de rappel chez l'adolescent (11-13 ans en France) ou le « cocooning » qui consiste à vacciner toute personne en contact étroit et durable avec un nourrisson de moins de six mois[14],[28].
Autres facteurs de résurgence
Les autres causes sont nombreuses, mais le plus souvent considérées comme secondaires ou controversées. Il peut s'agir de politique vaccinale : baisse de couverture vaccinale, hésitation ou opposition vaccinale (poches de population non ou sous-vaccinées), modifications du calendrier vaccinal (âges de la primovaccination et des rappels)[6],[8].
Des auteurs insistent sur des facteurs biologiques comme des évolutions de B. pertussis sous pression vaccinale (apparition de nouveaux variants devenus plus contagieux). D'autres sur des meilleurs systèmes de surveillance ou de diagnostic (comme la PCR) qui amènent à reconnaitre un plus grand nombre de cas[29].
Traitement
Les malades doivent être isolés, à l'hôpital comme au domicile familial, avec des mesures de protection (masque chirurgical et hygiène des mains). La durée de l'isolement est de 3 semaines en l'absence de traitement, et de 5 jours avec une antibiothérapie adaptée, abaissée à 3 jours en cas de traitement par azithromycine[14].
Antibiothérapie
Le traitement fait appel essentiellement à des antibiotiques (macrolides) dans les trois premières semaines d'évolution. Les deux macrolides privilégiés sont l'azithromycine et la clarithromycine[14],[30].
L'antibiothérapie permet d'éliminer la présence de la bactérie dans le rhinopharynx, de réduire la période de contagiosité, et limiter la transmission à l'entourage. Elle a peu d'influence sur la fréquence et l'intensité des quintes et sur la durée de la maladie[14].
Des souches de B. pertussis résistantes aux macrolides ont été signalées en Chine, mais elles restent rares en Europe et en Amérique du Nord[30],[31].
Le cotrimoxazole est utilisé comme alternative en cas de contre-indication ou de mauvaise tolérance aux macrolides[6],[12].
Autres traitements
Les traitements symptomatiques (fluidifiants, antitussifs, salbutamol, corticoïdes…) restent discutés au cours de la coqueluche, car mal évalués. Ils sont inutiles et non recommandés en général[14],[32]. La kinésithérapie respiratoire est contre-indiquée à la période des quintes.
Formes graves
L’hospitalisation est fortement recommandée pour les nourrissons de moins de 3 mois, et elle est justifiée pour les nourrissons plus âgés en fonction de leur état clinique. Elle permet de mettre en place une surveillance plus étroite, notamment respiratoire, et d'assurer un nursing adapté (hydratation et nutrition) pendant la phase aiguë[14].
Un échange plasmatique peut être proposé au cours de formes malignes[6],[14].
Prévention
Mesures collectives
En France, les cas groupés de coqueluche (plus de deux) survenant dans une collectivité doivent être signalés au médecin inspecteur de santé publique de l'ARS par tout médecin en ayant connaissance[14]. L'objectif est non seulement de traiter le ou les cas index, mais aussi d'éviter les cas secondaires par prévention directe pour les cas contacts[12]. Aux États-Unis, le délai médian, entre le début d'une épidémie de coqueluche et la mise en œuvre de contre-mesures est de 40 jours[6].
En France, l'éviction scolaire pour coqueluche est fixée à 21 jours après le début de la toux., mais peut être réduite à 5 jours après antibiothérapie et à 3 jours s'il s'agit d'azithromycine[33]. Il n'y a pas d'éviction pour les sujets contacts asymptomatiques[14].
Une antibiothérapie préventive est recommandée pour les personnes de l'entourage proche du malade, notamment les sujets à risques (susceptibles de faire une forme grave de coqueluche, de décompenser une maladie sous-jacente, femmes enceintes….)[14].
En France, les personnes considérées comme protégées par la vaccination contre la coqueluche sont[14] :
- les nourrissons âgés de 11 mois ou moins ayant reçu deux doses de vaccin ;
- les enfants âgés de plus de 11 mois ayant reçu trois doses de vaccin, dont un rappel, la dernière dose remontant à moins de 5 ans ;
- les adolescents âgés de plus de 16 ans, et les adultes ayant reçu une dose de vaccin depuis moins de cinq ans, quel que soit le nombre de doses antérieures.
Antibiothérapie préventive
Le traitement préventif est identique au traitement curatif. Il concerne les cas contacts définis plus haut : contacts proches (personnes vivant sous le même toit, flirts, pensionnaires et professionnels de la même crèche) et contacts occasionnels (sujets à risque de l'entourage professionnel ou de la collectivité). Les mesures dépendent du niveau d'exposition, des délais d'incubation et de contamination[12].
Si un cas contact présente des symptômes, il est considéré comme un cas de traitement curatif en étant isolé. Les cas contacts mis sous antibiotiques qui restent sans symptômes n'ont pas besoin d'être isolés. Les sujets contacts qui ne sont pas à jour du calendrier vaccinal sont vaccinés[14].
Dans les collectivités (crèches, écoles, services hospitaliers…), une stratégie globale d'information des parties prenantes est nécessaire pour établir les mesures préventives nécessaires[12],[14].
Vaccination
Il existe deux principaux types de vaccins :
Vaccins anti-coquelucheux à germes entiers
Ces vaccins à germes entiers sont constitués de la bactérie entière Bordetella pertussis, inactivée à la chaleur ou chimiquement. Ces vaccins sont généralement constitués de plusieurs souches bactériennes exprimant différents antigènes[34].
Leur efficacité est variable, de par les différences de composition selon les fabricants, et les différences d'utilisation (calendrier vaccinal) selon les pays. Classiquement de 90 % ou plus, à moins de 50 % selon les études. La durée de protection est de l'ordre de 7 à 9 ans après 4 doses[34].
Ces vaccins sont ceux qui ont le plus d'effets secondaires parmi l'ensemble des vaccins utilisés en routine : le plus souvent mineurs (50 % des vaccinés) ou modérés (pleurs prolongés inconsolables de plus d'une heure, survenant dans les heures qui suivent une vaccination) chez 3 à 4 % des vaccinés[30]. Plus rares sont les convulsions fébriles (1 sur 2000). Les effets indésirables très graves signalés dans les années 1970-1980 n'ont pas été confirmés, mais cela a mené quelques pays à suspendre cette vaccination, et à la remplacer par d'autres vaccins dits acellulaires (voir section Histoire)[34].
En France, le vaccin à germes entiers utilisé étant jugé efficace, il a été maintenu, au moins pour la primovaccination, jusqu'en 2005 pour être abandonné (rendu non disponible) en janvier 2006[34].
Vaccins anti-coquelucheux acellulaires
Ces vaccins sont constitués directement à partir de protéines antigéniques (sans bactéries entières). Ils comportent de 2 à 5 antigènes : tous ces vaccins contiennent au moins la PT (Pertussis Toxin) d'autres contiennent en plus d'autres antigènes de type adhésine, de composition variable selon les fabricants[10].

Ils sont habituellement administrés en combinaison avec d'autres vaccins (trivalents à hexavalents) en intramusculaire (cuisse chez l'enfant de moins d'un an, épaule pour les autres tranches d'âge). Ils sont plus coûteux que les vaccins à germes entiers, ce qui a retardé leur adoption dans les pays développés[10].
Ils ont une efficacité de l'ordre de 80 à 85 %, inférieure de 5 à 10 % aux vaccins à germes entiers[10]. Des études expérimentales (primates non humains en laboratoire) suggèrent qu'ils n'auraient pas ou peu d'effets sur la transmission et l'immunité grégaire, cependant elles sont contredites par des études épidémiologiques de terrain qui montrent que ces vaccins procurent une immunité collective efficace[6],[14].
Ils présentent moins d'effets secondaires lors de la primo-vaccination, mais la fréquence des réactions locales tend à augmenter avec l'âge et le nombre d'injections[10], d'où des vaccins à dose réduite de la valence coqueluche pour les rappels (à partir de l'âge de 6 ans)[14].
Les études sur les effets indésirables des vaccinations maternelles n'ont pas montré d'effets indésirables graves chez la mère et l'enfant[35]. Une étude en Angleterre portant sur 20 074 femmes ayant reçu le vaccin durant leur grossesse montre qu'il n'y a pas de preuve de risques accrus pour la mère et l'enfant à naître[36].
Ces vaccins peuvent conduire à sélectionner des souches résistantes ne produisant par exemple pas de pertactine[37].
Politiques vaccinales
Selon l'OMS, le but principal de la vaccination anti-coqueluche est de réduire le risque de coqueluche grave chez les nourrissons et les petits enfants. L'OMS préconise une primo-vaccination de 3 doses, à partir de l'âge de 6 semaines et avant 6 mois, chaque dose étant espacée de 4 à 8 semaines, pour tous les enfants dans le monde, y compris ceux positifs pour le VIH[10].
Pour les doses de rappel, cela dépend du choix des vaccins, de l'épidémiologie locale et de la durée de protection conférée par la primovaccination, évaluation qui est faite par des programmes nationaux propres à chaque pays. Il existe ainsi plus de 80 calendriers de vaccination susceptibles d'évoluer et de se modifier selon les résultats du système de surveillance[10].
En France, la vaccination anti-coqueluche est obligatoire pour tous les enfants nés depuis le . Il s'agit d'une primovaccination réalisée avec un vaccin hexavalent en deux doses (2e et 4e mois) suivies d'un rappel à 11 mois. Les autres rappels s'effectuent à 6 ans (avec un vaccins tétravalent) et à 11-13 ans (vaccin tétravalent à dose coqueluche réduite). Pour les adultes, un rappel est recommandé à partir de 25 ans jusqu'à 39 ans[38].
Femmes enceintes
En raison d'une recrudescence du nombre de cas de coqueluche dans le monde[35], il est recommandé (OMS 2015) aux femmes enceintes de se faire vacciner[39]. Cette vaccination augmente le transfert des anticorps maternels à travers le placenta et diminue le risque de coqueluche chez les nouveau-nés[38],[40]. Cette vaccination s'effectue généralement au 2e trimestre de chaque grossesse (16e à 32e semaine de chaque grossesse) avec un vaccin à dose coqueluche réduite[39].
En 2023, cette vaccination des femmes enceintes est recommandée aux États-Unis et au Canada ; dans au moins 8 pays d'Europe (France, à la 20e-36e semaine de grossesse[38]) ; dans plus d'une douzaine de pays d'Amérique Latine. Elle n'est pas utilisée dans les pays d'Afrique, d'Asie, du Moyen-Orient et du Pacifique, à l'exception de l'Australie, Hong-Kong, Corée du Sud, Malaisie, Nouvelle-Zélande et Singapour[39].
Stratégie de « cocooning »
Elle consiste à protéger les nourrissons trop jeunes pour être vaccinés, par la vaccination de leurs contacts. Cette stratégie est recommandée dans plusieurs pays développés (dont l'Allemagne, la France, l'Australie…)[10]. En France, sont concernés les adultes ayant un projet parental et les personnes en contact étroit et durable avec un nourrisson de moins de 6 mois (contacts familiaux, professionnels de la petite enfance, personnel soignant…)[38]. Cette stratégie est précisée par l'avis de la Haute Autorité de santé du 22 juillet 2024[41].
La valeur de cette stratégie est discutée en raison de la difficulté à la mettre en œuvre (nécessité d'une forte couverture vaccinale des personnes concernées)[10] et de doutes sur son efficacité (personnes immunisées transmettant la maladie)[42]. Les études sont contradictoires (effet fort, faible ou nul) selon les pays[10],[28],[29]. Aux États-Unis, la préférence est donnée à la vaccination des femmes enceintes[42].
Recherche vaccinale
Elle se porte sur de nouveaux vaccins, plus efficaces et plus sûrs : nouveaux adjuvants, adaptation aux nouvelles souches de B. pertussis, utilisation du génie génétique (dont le coût diminue)[6],[29].
Le vaccin expérimental le plus avancé, le BPZE1 est en essai de phase 2. Il s'agit d'un vaccin vivant introduit par voie nasale constitué de la bactérie modifiée par génie génétique[43],[44]: le gène de la toxine dermonécrotique est excisé, le gène de la cytotoxine trachéale remplacé par un gène hétérologue d'E. coli (gène ampG) et le gène de la toxine pertussique inactivé par remplacement d'acides aminés (Arg 9 remplacé par Lys, glu 129 remplacé par Gly[45].
Histoire
Premières mentions
_by_Sa'di%253B_verso-_the_Prophet_and_the_Persian_physician%253B_recto-_te..._-_Google_Art_Project.jpg)
L'histoire de la coqueluche avant le XXe siècle n'est pas claire. En 1886, l'historien allemand August Hirsch suggère que cette maladie serait apparue en Europe du nord au XVIe siècle. D'autres évoquent une origine orientale comme la Côte de Malabar[46]. En 1930, le bactériologiste français Charles Nicolle écrivait « la fièvre méditerranéenne est, sans doute, le meilleur exemple que nous puissions donner d'une maladie d'origine récente ; ce n'est pas le seul (…) La coqueluche n'est point, non plus, très ancienne »[47].
La maladie n'est pas décrite dans les textes médicaux de l'antiquité et du moyen-âge, soit parce qu'elle n'existait pas ou peu, soit parce qu'elle était « inapparente » aux yeux des médecins d'autrefois en étant confondue avec d'autres causes de surmortalité infantile (nourrissons et enfants en bas âge)[48].
Des études récentes suggèrent que la coqueluche serait mentionnée en Chine sous la dynastie Sui au VIIe siècle par Chao Yuanfang (en) sous l'appellation de « toux des cent jours »[6],[49]. En Perse, sous les Timurides, Baha Al-Dowleh Razi (ne pas confondre avec Rhazès) dit aussi Nurbakhshi (en) (1455-1509) aurait signalé trois épidémies de coqueluche à Herat et Ray survenues vers 1500 [50],[51].
En Europe, l'épidémie survenue à Paris en 1414 (où le terme de coqueluche/capuche apparait) est plutôt vue comme une épidémie de grippe sévère, tandis que la maladie décrite dans un texte coréen de 1433 serait plutôt le croup de la diphtérie[51].
La première description clinique de la maladie (clairement reconnue par les historiens) est celle du français Guillaume de Baillou (1538-1616), lors d'une épidémie sévère frappant les enfants de Paris au cours de l'été-automne de 1578. Selon lui, cette maladie portait déjà plusieurs noms populaires, sans être médicalement reconnue et il la nomme Tussis quintina, Tussis quintana ou Tussis quinta (toux avec une périodicité de 5 heures)[6],[50].
En Angleterre, la maladie est dite chyme cough (toux glaireuse) et William Harvey (1578-1657) en fait une maladie digestive de l'estomac. Puis elle est vue comme une maladie respiratoire de poitrine : Thomas Willis (1621-1675) décrit la tussis puerorum convulsiva dont la chincough (toux du menton) comme une forme longue à guérir mais rarement fatale, tandis que Thomas Sydenham (1624-1689) insiste sur la whooping cough (toux criarde) comme une forme sévère nécessitant un traitement d'urgence rigoureux[46],[52].
Épidémiologie historique
Les premières statistiques considérées comme fiables sur la coqueluche sont celles du suédois Nils Rosén von Rosenstein (1706-1773) qui en fait une maladie infantile courante, de gravité variable. En Angleterre, en 1701, les termes chincough et whooping cough apparaissent comme des causes de mortalité dans les Bills of Mortality (en) (registres de mortalité) de la ville de Londres. Au cours du XVIIIe siècle, ces premières statistiques (Suède, Angleterre) indiquent une augmentation continue des décès attribués à la coqueluche, par exemple à Londres, sur deux périodes de 15 ans, de 119 décès (1702-1717) à 4252 (1762-1777)[46].

En Angleterre et au Pays de Galles, la mortalité par coqueluche atteint un pic dans les années 1870 : de l'ordre de 1500 décès annuels par million d'enfants de moins de 15 ans. Cette mortalité touche surtout les enfants des classes laborieuses, le décès étant le plus souvent lié à des complications respiratoires. À partir des années 1880, le taux de létalité commence à décliner, surtout en zone rurale, alors que dans les zones urbaines et industrielles, le déclin est plus lent : de 10 % (années 1880) à 1,1 % (dans les années 1940)[46].
Aux États-Unis, la coqueluche devient une maladie à déclaration obligatoire en 1922[46]. Jusqu'aux années 1940, 115 000 à 270 000 cas sont signalés chaque année, dont 5 000 à 10 000 décès. Avec la généralisation de la vaccination, le taux d'incidence de la coqueluche est réduit de 99 % (des années 1940 aux années 1970). Le point le plus bas est atteint en 1976 (mille cas) mais une résurgence se produit depuis les années 1980[21].
Microbiologie et vaccins

Bactéries
L'agent de la coqueluche – du moins l'agent principal –, la bactérie Bordetella pertussis, a été découvert par Jules Bordet et Octave Gengou dès 1900, mais son isolement n'a été réalisé par ces mêmes médecins qu'en 1906 après la mise au point du premier milieu de culture à base d'extrait de pommes de terre (milieu de Bordet et Gengou)[52].
La maladie fut reproduite pour la première fois en 1908 par Klimenko[55] chez le singe et le chien. Bordetella parapertussis, qui à la différence de B. pertussis n'est pas strictement humaine, fut isolée en 1938 par Eldering et Kendrick[56] : la maladie est appelée coqueluche lorsqu'il s'agit de B. pertussis et paracoqueluche lorsqu'il s'agit de B. parapertussis[52].
Vaccins historiques
Dès 1913, Charles Nicolle propose un vaccin, qui ne donna pas satisfaction. En 1914, le premier vaccin contre la coqueluche est commercialisé aux États-Unis. Comme d'autres vaccins anticoqueluche de première génération (1913-1933), ces vaccins étaient obtenus par des moyens empiriques (préparations à partir de milieu de culture, en plusieurs injections intramusculaires ou sous-cutanées), et ils étaient utilisés à la fois comme moyen de traitement et de prévention, d'efficacité dite « inconstante »[57],[58].
Une meilleure compréhension des phases de croissance de B. pertussis conduit au raffinement des méthodes, notamment de purification, pour aboutir à des vaccins de deuxième génération, de façon standardisée et reproductible : c'est la mise au point, dans les années 1930, de vaccins à germe entier (bactéries tuées par la chaleur). C'est aussi le début des essais cliniques contrôlés du vaccin anticoqueluche selon des standards internationaux, notamment par les travaux de Pearl Kendrick et Grace Eldering (en)[58],[59].
Vaccins à germe entier
Le vaccin anti-coqueluche a été recommandé aux États-Unis en 1944. Il s'administrait presque toujours chez les enfants en combinaison avec les vaccins contre la diphtérie et le tétanos[58],[59] (vaccin trivalent DTP Diphteria Tetanos Pertussis, ne pas confondre avec le vaccin DTP français Diphtérie Tétanos Polio).

En France, le premier vaccin coquelucheux a été introduit en 1959 (Vaxicoq) et la vaccination s'est généralisée à partir de 1966 grâce à l'introduction d'un vaccin quadrivalent combiné associant les vaccins contre la diphtérie, le tétanos et la poliomyélite (DTCP et Tetracoq). Le maintien d'une bonne couverture vaccinale a permis de réduire de façon spectaculaire la morbidité et la mortalité coquelucheuse[60]. En 1995, le vaccin anticoquelucheux est aussi présent dans un vaccin pentavalent, avec en sus le composant haemophilus influenzae (Pentacoq).
Aux États-Unis, dans les années 1970, plusieurs controverses éclatent sur la vaccination contre la coqueluche : sur la véritable fréquence d'effets secondaires graves, notamment les encéphalopathies avec séquelles définitives, et la mort subite du nourrisson. Ces informations largement médiatisées ont conduit à une perte de confiance du public (chute des taux de vaccinations, hausse des plaintes, fabricants de vaccins se retirant du marché) et à une situation de crise profonde du programme américain de vaccination, aboutissant à la création du National Vaccine Injury Compensation Program (en) pour dédommager les victimes présumées et leur famille[61],[62].
Plusieurs pays ont alors plus ou moins abandonné la vaccination contre la coqueluche : Grande-Bretagne, Suède, Allemagne et Japon, entraînant le retour d'épidémies sévères. Par la suite, plusieurs études n'ont pas confirmé une augmentation de risque d'accidents neurologiques graves après vaccination à germe entier. La Grande-Bretagne a repris la vaccination avec le même vaccin, et la Suède l'a arrêtée jusqu'en 1996 en utilisant depuis le nouveau vaccin acellulaire[34],[62].
Vaccins acellulaires
Les craintes du public concernant le vaccin à germe entier n'ont pas été levées par des études scientifiques, mais par le remplacement des anciens vaccins par de nouveaux dit acellulaires[62]. Ces vaccins ont été mis au point au Japon, basés non plus sur la bactérie entière, mais sur quelques antigènes (principalement la Pertussis toxin (en))[58].

Les résultats encourageants du Japon incitent les pays industrialisés à développer d'autres vaccins acellulaires. Progressivement ces nouveaux vaccins remplacent les anciens, en Amérique du Nord et en Australie, dans la plupart des pays d'Europe (France 2006[34] ), et dans quelques pays d'Asie et d'Amérique latine, dans les années 1990-2000[58].
Traitements
La diversité des thérapeutiques, chacune présentée en son temps comme « radicale », est considérable[16]. En médecine mapuche, les mères utilisaient l'héliothérapie en menant leurs enfants tousseurs au sommet d'un volcan pour jouer une journée entière sous le soleil[63].
En Occident, outre les traitements par ostéopathie[64] ou par homéopathie, il existe de nombreuses médications utilisées par les médecins pour calmer la toux de la coqueluche telles que la teinture de drosera, celle de belladone, des somnifères, le chlorhydrate de morphine, le bromoforme, chloroforme ou fluoroforme. En Allemagne, au début du XXe siècle, la quinine est le plus souvent utilisée. En France, des auteurs proposent des injections sous-cutanées de lait ou des intra-musculaires d'éther[16],[63].
Le goudron de Norvège, utilisé par voie orale, est très populaire jusqu'au début du XXe siècle. De fortes doses de vitamine D2 ou de vitamine C ont été préconisées. Il en est de même pour les agents physiques, comme les ultra-violets, l'ozonothérapie ou la radiothérapie [16],[65],[63].

Dans la première moitié du XXe siècle, des médecins proposent la « pneumothérapie » par air comprimé, par exemple en plaçant l'enfant sur le siège avant d'une automobile découverte allant jusqu'à 145 km/h[63]. Des essais en caisson dépressurisé ont même été conduits[66],[67].
Dans les années 1940 à 1960, les bienfaits d'un passage en altitude pour soigner cette maladie sont étudiés[63]. De nombreux enfants ont ainsi eu droit à un baptême de l'air, à l'occasion d'une coqueluche, parfois appelé « vol coqueluche ». Le docteur Jules Crochet, aviateur et médecin, pratiquait cette méthode à Reims (France)[68].
L'ensemble de ces méthodes, considérées comme historiques, a été abandonné, faute de répondre aux principes de médecine fondée sur les faits, notamment une définition claire des critères de diagnostic de coqueluche, et des essais cliniques contrôlés[69].
Bibliographie
- (en) Walter A. Orenstein (dir.) et Kathryn M. Edwards, Plotkin's Vaccines, Philadelphia, Elsevier, , 8e éd., 1782 p. (ISBN 978-0-32379058-1), chap. 45 (« Pertussis Vaccines »), p. 763-815.
Notes et références
- ↑ TLFi, Accès au direct à l'article dans le TLFi
- 1 2 3 Alain Rey, Dictionnaire historique de la langue française, Paris, Le Robert, , 6e éd., 1456 p. (ISBN 978-2-32101-650-2), p. 621.
- ↑ Joop f p Schellekens, « Pertussis: a concise historical review including diagnosis, incidence, clinical manifestations and the role of treatment and vaccination in management », Reviews in Medical Microbiology, (lire en ligne, consulté le )
- ↑ A. Manuila, Dictionnaire français de médecine et de biologie, vol. 1, Masson, , p. 719 et 844.
- ↑ Florian Lecorvaisier, « Impact de la vaccination sur l’évolution de Bordetella pertussis », Médecine/Sciences, vol. 40, no 2, , p. 161 (DOI 10.1051/medsci/2023219, lire en ligne, consulté le )
- 1 2 3 4 5 6 7 8 9 10 11 12 13 14 15 16 17 18 19 20 21 22 23 24 Paul E. Kilgore, Abdulbaset M. Salim, Marcus J. Zervos et Heinz-Josef Schmitt, « Pertussis: Microbiology, Disease, Treatment, and Prevention », Clinical Microbiology Reviews, vol. 29, no 3, , p. 449–486 (ISSN 1098-6618, PMID 27029594, PMCID 4861987, DOI 10.1128/CMR.00083-15, lire en ligne, consulté le )
- 1 2 Orenstein 2024, p. 765.
- 1 2 3 4 Nicole Guiso, « Pourquoi la coqueluche est-elle toujours une maladie d'actualité ? », La Revue du Praticien, vol. 55, , p. 1287-1292.
- 1 2 3 Delma J. Nieves et Ulrich Heininger, « Bordetella pertussis », Microbiology Spectrum, vol. 4, no 3, (ISSN 2165-0497, PMID 27337481, DOI 10.1128/microbiolspec.EI10-0008-2015, lire en ligne, consulté le )
- 1 2 3 4 5 6 7 8 9 10 11 12 13 14 (en) « Pertussis vaccines: WHO position paper – August 2015 », sur www.who.int (consulté le )
- ↑ Dr Jean-François Lemoine, émission « Pourquoi docteur ? » sur Europe 1, 7 octobre 2012
- 1 2 3 4 5 6 7 8 9 10 11 Nicole Guiso et Jacques Gaillat, « Coqueluche », La Revue du Praticien, vol. 65, , e149-e154.
- 1 2 3 4 5 6 Joël Gaudelus et Emmanuel Grimprel, « Coqueluche », La Revue du Praticien, vol. 60, , p. 425-430.
- 1 2 3 4 5 6 7 8 9 10 11 12 13 14 15 16 17 18 19 20 21 22 23 24 25 26 27 28 29 30 P. Delobel, E. Pilly Maladies infectieuses et tropicales, Paris, Alinéa Plus, , 27e éd., 720 p. (ISBN 978-2-916641-68-3), chap. 65 (« Coqueluche »), p. 334-337.
- ↑ « Fiche coqueluche » www.pasteur.fr
- 1 2 3 4 5 J. Marie et R. Dailly, « Coqueluche, étude clinique », Encyclopédie médico-chirurgicale, maladies infectieuses, no fascicule 8017 B, , p. 1-9.
- ↑ Grimprel E. « La coqueluche en pratique en 2006 » Revue française d'allergologie et d'immunologie clinique 2006 ;46 :548-551.
- 1 2 Fatima Aït El Belghiti, « Epidémiologie de la coqueluche en France » [PDF],
- ↑ « Coqueluche et autres bordetelloses », sur Institut Pasteur, (consulté le )
- ↑ « Recrudescence de la coqueluche en Europe, appel à une vigilance renforcée en France », sur www.santepubliquefrance.fr (consulté le )
- 1 2 3 4 5 6 7 8 9 Orenstein 2024, p. 772-776.
- ↑ OMS, « Note de synthèse : position de l'OMS concernant les vaccins anticoquelucheux », Relevé épidémiologique hebdomadaire, vol. 85, no 40, , p. 386. (lire en ligne [PDF])
- ↑ (en) S. Gilberg, E. Njamkepo, I. Parent du Châtelet et al. Evidence of Bordetella pertussis Infection in Adults Presenting with Persistent Cough in a French Area with Very High Whole‐Cell Vaccine Coverage. The Journal of Infectious Diseases 2002;186:415–418
- ↑ Office fédéral de la santé publique OFSP, « Coqueluche / Pertussis », sur bag.admin.ch (consulté le )
- ↑ (en) Marion Debin, Titouan Launay, Louise Rossignol1, Fatima Ait El Belghiti, Sylvain Brisse, Sophie Guillot, Nicole Guiso, Daniel Levy-Bruhl, Lore Merdrignac, Julie Toubiana, Thierry Blanchon, Thomas Hansli, « Pertussis surveillance results from a French general practitioner network, France, 2017 to 2020 », Euro Surveill., vol. 27, no 17, (PMID 35485270, DOI 10.2807/1560-7917.ES.2022.27.17.2100515, lire en ligne, consulté le ).
- ↑ SPF, « Coqueluche en France. Point au 29 juillet 2024. », sur www.santepubliquefrance.fr (consulté le )
- ↑ Nicola P. Klein, Joan Bartlett, Ali Rowhani-Rahbar et Bruce Fireman, « Waning protection after fifth dose of acellular pertussis vaccine in children », The New England Journal of Medicine, vol. 367, no 11, , p. 1012–1019 (ISSN 1533-4406, PMID 22970945, DOI 10.1056/NEJMoa1200850, lire en ligne, consulté le )
- 1 2 Orenstein 2024, p. 808.
- 1 2 3 Xuanxuan Nian, Hongbo Liu, Mengyao Cai et Kai Duan, « Coping Strategies for Pertussis Resurgence », Vaccines, vol. 11, no 5, , p. 889 (ISSN 2076-393X, PMID 37242993, DOI 10.3390/vaccines11050889, lire en ligne, consulté le )
- 1 2 3 Michael D. Decker et Kathryn M. Edwards, « Pertussis (Whooping Cough) », The Journal of Infectious Diseases, vol. 224, no 12 Suppl 2, , S310–S320 (ISSN 1537-6613, PMID 34590129, PMCID 8482022, DOI 10.1093/infdis/jiaa469, lire en ligne, consulté le )
- ↑ Orenstein 2024, p. 771.
- ↑ Kay Wang, Silvana Bettiol, Matthew J. Thompson et Nia W. Roberts, « Symptomatic treatment of the cough in whooping cough », The Cochrane Database of Systematic Reviews, vol. 2014, no 9, , p. CD003257 (ISSN 1469-493X, PMID 25243777, PMCID 7154224, DOI 10.1002/14651858.CD003257.pub5, lire en ligne, consulté le )
- ↑ Ministère des affaires sociales, de la santé et des droits des femmes, « Instruction DGS/RI1 no 2014-310 du 7 novembre 2014 relative à la conduite à tenir devant un ou plusieurs cas de coqueluche » [PDF], sur solidarites-sante.gouv.fr, (consulté le )
- 1 2 3 4 5 6 Joël Gaudelus (dir.) et Nicole Guiso, Vaccinologie, Rueil-Malmaison, Doin, , 463 p. (ISBN 978-2-7040-1243-5), p. 150-160.
- 1 2 (en) Frits R. Mooi et Sabine C. de Greeff, « The case for maternal vaccination against pertussis », The Lancet. Infectious Diseases, vol. 7, no 9, , p. 614–624 (ISSN 1473-3099, PMID 17537674, DOI 10.1016/S1473-3099(07)70113-5, lire en ligne, consulté le )
- ↑ (en) Phil Bryan, Bridget King et Katherine Donegan, « Safety of pertussis vaccination in pregnant women in UK: observational study », BMJ, vol. 349, , g4219 (ISSN 1756-1833, PMID 25015137, DOI 10.1136/bmj.g4219, lire en ligne, consulté le )
- ↑ « Les leçons des vaccins contre la coqueluche », Le Monde, (lire en ligne, consulté le )
- 1 2 3 4 « Le calendrier des vaccinations - Ministère du travail, de la santé et des solidarités », sur sante.gouv.fr (consulté le ), p. 8-10.
- 1 2 3 Orenstein 2024, p. 811-812.
- ↑ (en) Nicola P. Klein, Edwin Lewis, Bruce Fireman et Joan Bartlett, « Effectiveness of Vaccination During Pregnancy to Prevent Infant Pertussis », Pediatrics, vol. 139, no 5, , e20164091 (ISSN 0031-4005 et 1098-4275, PMID 28557752, DOI 10.1542/peds.2016-4091, lire en ligne, consulté le )
- ↑ « Stratégie de vaccination contre la coqueluche dans le contexte épidémique de 2024. Rappel vaccinal des professionnels au contact des personnes à risque de forme grave », sur Haute Autorité de Santé (consulté le )
- 1 2 Jonathan M. Kline, Eleanor A. Smith et Adrienne Zavala, « Pertussis: Common Questions and Answers », American Family Physician, vol. 104, no 2, , p. 186–192 (ISSN 1532-0650, PMID 34383446, lire en ligne, consulté le )
- ↑ Graziella Cara, « Contre la coqueluche et sa transmission, un nouveau vaccin intranasal sûr et plus efficace », sur Salle de presse de l'Inserm, (consulté le )
- ↑ Orenstein 2024, p. 814.
- ↑ « ILiAD Biotechnologies » (consulté le )
- 1 2 3 4 5 (en) Kenneth F. Kiple (dir.) et Anne Hardy, The Cambridge World History of Human Disease, Cambridge, Cambridge University Press, , 1176 p. (ISBN 0-521-33286-9), chap. VIII.156 (« Whooping Cough »), p. 1094-1096.
- ↑ Charles NICOLLE, Destin des maladies infectieuses] ; Leçons du Collège de France ; "Les classiques des sciences sociales" Une bibliothèque numérique, PDF, 196 pages (voir p. 108/196)
- ↑ Mirko D. Grmek, Les maladies à l'aube de la civilisation occidentale, Paris, Payot, coll. « Médecine et Sociétés », , 527 p. (ISBN 978-2-228-55030-7, BNF 34724763), p. 477..
- ↑ Yan Liang, Abdulbaset M. Salim, Wendy Wu et Paul E. Kilgore, « Chao Yuanfang: Imperial Physician of the Sui Dynasty and an Early Pertussis Observer? », Open Forum Infectious Diseases, vol. 3, no 1, , ofw017 (ISSN 2328-8957, PMID 26977422, PMCID 4786867, DOI 10.1093/ofid/ofw017, lire en ligne, consulté le )
- 1 2 Orenstein 2024, p. 763.
- 1 2 Arash Aslanabadi, Kamyar Ghabili, Kaveh Shad et Majid Khalili, « Emergence of whooping cough: notes from three early epidemics in Persia », The Lancet. Infectious Diseases, vol. 15, no 12, , p. 1480–1484 (ISSN 1474-4457, PMID 26298206, PMCID 7164782, DOI 10.1016/S1473-3099(15)00292-3, lire en ligne, consulté le )
- 1 2 3 Nicole Guiso, « Historique de la coqueluche », sur Pasteur.fr
- ↑ « Les causes de décès en France depuis 1925 » INED, consulté le 26 avril 2013
- ↑ Henri Bonnemain, « Ange-Denis Ronchèse (1882-1967) et les ampho-vaccins », Revue d'Histoire de la Pharmacie, vol. 74, no 271, , p. 305–307 (DOI 10.3406/pharm.1986.3341, lire en ligne, consulté le )
- ↑ https://www.ncbi.nlm.nih.gov/pmc/articles/PMC2130499/pdf/jhyg00077-0068.pdf
- ↑ http://jb.asm.org/cgi/reprint/35/6/561.pdf
- ↑ T Jefferson, « Why the MRC randomized trials of whooping cough (pertussis) vaccines remain important more than half a century after they were done », Journal of the Royal Society of Medicine, vol. 100, no 7, , p. 343–345 (ISSN 0141-0768, PMID 17606757, PMCID 1905874, lire en ligne, consulté le )
- 1 2 3 4 5 Orenstein 2024, p. 778.
- 1 2 (en) Shapiro-Shapin Cg, « Pearl Kendrick, Grace Eldering, and the pertussis vaccine », Emerging infectious diseases, vol. 16, no 8, 2010 aug (ISSN 1080-6059, PMID 20678322, DOI 10.3201/eid1608.100288, lire en ligne, consulté le )
- ↑ Joël Gaudelus (dir.) et Pierre Bégué, Vaccinologie, Rueil-Malmaison, Doin, , 463 p. (ISBN 978-2-7040-1243-5), p. 116-118.
- ↑ (en) Regina Rabinovich et Anthony Robbins, « Pertussis Vaccines: A Progress Report », JAMA, vol. 271, no 1, , p. 68–69 (ISSN 0098-7484, DOI 10.1001/jama.1994.03510250084042, résumé)
- 1 2 3 Orenstein 2024, p. 786-787.
- 1 2 3 4 5 Alejandro Donoso Fuentes, Dina Contreras Esteyes, Daniela Ulloa Vega et Daniela Arriagada Santis, « [Seventy years after the beginning of vaccination against pertussis. Brief historical review of the treatments used in its combat] », Andes Pediatrica: Revista Chilena De Pediatria, vol. 92, no 6, , p. 963–970 (ISSN 2452-6053, PMID 35506810, DOI 10.32641/andespediatr.v92i6.4059, lire en ligne, consulté le )
- ↑ Torsten Liem, « Osteopathic Manipulative Treatment for Pertussis in the 19th and 20th Centuries: A Structured Historical Literature Review », The Journal of the American Osteopathic Association, vol. 119, no 2, , p. 116–125 (ISSN 1945-1997, PMID 30688349, DOI 10.7556/jaoa.2019.018, lire en ligne, consulté le )
- ↑ Edward J. Calabrese, Gaurav Dhawan et Rachna Kapoor, « Radiotherapy for Pertussis: An Historical Assessment », Dose-Response: A Publication of International Hormesis Society, vol. 15, no 2, , p. 1559325817704760 (ISSN 1559-3258, PMID 28529467, PMCID 5424867, DOI 10.1177/1559325817704760, lire en ligne, consulté le )
- ↑ (en) « DECOMPRESSION TREATMENT OF WHOOPING-COUGH » [PDF], sur ncbi.nlm.nih.gov,
- ↑ (en) The British Medical Journal, BMJ Publishing Group, (lire en ligne)
- ↑ « Médecine Aéronautique », tome 5, no 1, 1er trimestre 1950.« Les variations de l'équilibre endocrinien au cours des vols thérapeutiques », par le Dr Crochet (Reims)
- ↑ J Broomhall et A Herxheimer, « Treatment of whooping cough: the facts. », Archives of Disease in Childhood, vol. 59, no 2, , p. 185–187 (ISSN 0003-9888, PMID 6367671, PMCID 1628466, lire en ligne, consulté le )
Voir aussi
Articles connexes
Liens externes
- Notices dans des dictionnaires ou encyclopédies généralistes :
- Ressources relatives à la santé :
- Ressource relative à la recherche :
- Portail des maladies infectieuses